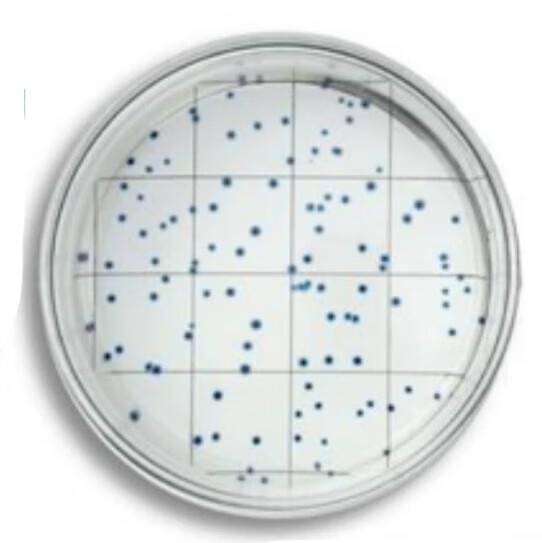
酶底物法菌落总数检测试剂水中细菌的菌落总数检测100个/箱 国产 100

酶底物法

酶底物法菌落总数检测试剂水中细菌的菌落总数检测100个/箱 国产 100
图片尺寸542x543
colimax-酶底物法水中大肠菌群检测系统
图片尺寸1024x768
酶底物法菌落总数检测试剂水中细菌的菌落总数检测100个/箱 国产 100
图片尺寸800x800
酶底法大肠菌群检测试剂 规格100袋/盒 泰林
图片尺寸1920x1920
51/97孔定量盘(酶底物法检测系统)
图片尺寸3999x3999
酶底物法Colitag检剂粪大肠培养程控定量封口机用 酶底物法培养基(100个)
图片尺寸800x800
酶底物法程控定量封口机
图片尺寸6720x4480 图片尺寸790x790
图片尺寸790x790
酶底物法培养基 colitag检测试剂 粪大肠培养 程控定量封口机试剂
图片尺寸1440x1440
全自动酶底物法判读系统
图片尺寸800x800
酶底物法水质检测仪# 采用酶底物法进行水质检测,精准快速地测定酥行
图片尺寸800x800
酶底物法大肠杆菌检测仪:高效精准的微生物检测利器
图片尺寸800x800
酶底物法无菌定量盘 97孔定量盘 51孔定量盘
图片尺寸750x750
总大肠杆菌在线传感器自动监测仪全自动水质分析仪酶底物法检测
图片尺寸750x750
智能程控定量封口机_酶底物法检测设备_海研生物
图片尺寸1170x455
程控定量封肠口机酶底物法疾控te
图片尺寸800x800
程控定量封口机总大肠菌群粪大肠菌群大肠埃希氏菌测定酶底物法
图片尺寸800x800
程控定量封口机检测盘 灭菌型 97孔定量盘 酶底物法
图片尺寸750x4631
酶底物法培养基 colitag检测试剂 粪大肠培养 程控定量封口机试剂
图片尺寸800x800
酶底物法培养基 colitag检测试剂 粪大肠培养 程控定量封口机试剂
图片尺寸800x800






图片尺寸790x790